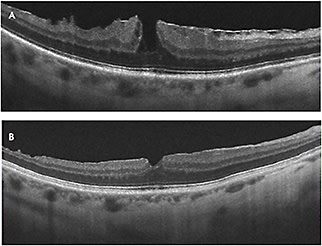

CONTROVERSIES IN CARE
Surgery for Non-full-thickness Macular Holes
EDITED BY MICHAEL COLUCCIELLO, MD
You may recall the controversy that occurred in 1991, when surgery was proposed for full-thickness macular holes (FTMHs), an issue that seems to be straight-forward at this time.1 Now, there is controversy regarding non-FTMHs. Is surgery warranted? If so, when? Should surgery be reserved for after vision is lost, or should it be considered before vision is lost?
It has been two years since we considered surgery for non-FTMHs in this column.2 Non-FTMHs consist of lamellar macular holes (LMHs) and macular pseudoholes (MPHs). Since then, surgical case series for the treatment of patients with vision symptoms associated with non-FTMHs have shown beneficial results, and the classification scheme has been questioned.
With regard to the classification issue: Are MPH and LMH part of a spectrum of non-FTMHs, or are they distinct entities? If they are in the same spectrum, surgery should be considered for either entity.
Michael Colucciello, MD, is a partner at South Jersey Eye Physicians and a clinical associate at the University of Pennsylvania/Scheie Eye Institute, Philadelphia, PA. He is a member of the Retina Society and the American Society of Retina Specialists. He has no financial disclosures to report. Dr. Colucciello can be reached via e-mail at maculamd@gmail.com.
Jay S. Duker, MD, is the director of the New England Eye Center and professor and chair of ophthalmology at Tufts University School of Medicine in Boston, MA. He reports no financial interests in any of the products mentioned here.
Rishi P. Singh, MD, is a staff physician at the Cole Eye Institute of the Cleveland Clinic in Ohio. He reports no financial interest in any of the products mentioned here.
The foveal contour is below the outer plexiform layer in both LMH and MPH. Some retinal physicians consider these entities to be simply different manifestations of a common process, with the attached posterior vitreous cortex and/or epiretinal membrane exerting traction from the optic nerve or vitreous base in a “typical” LMH (perhaps with cleavage planes) vs toward the fovea in the case of a “typical” MPH.
Those who feel that these entities are part of a spectrum point out that MPH and LMH may be observed in the same eye during the same examination just a few micrometers apart on another B-scan OCT image, and MPHs have been observed to evolve into LMHs.3 This view is not shared by all practitioners, however.
The natural history of non-FTMHs can be poor.4 Prolonged macular traction can cause irreversible photoreceptor cell loss and changes in photoreceptor alignment. A disrupted ellipsoid zone in non-FTMH may result from prolonged ERM-associated macular traction.5 Preoperative visual acuity, photoreceptor ellipsoid zone integrity, and foveal thickness correlate with visual outcomes after vitrectomy in patients with non-FTMHs.6
Recent published surgical case series have shown benefit in the vast majority of patients with non-FTMHs with pars plana vitrectomy, internal limiting membrane delamination, and fluid-gas exchange.7,8 Patients with non-FTMHs secondary to issues other than primary vitreomacular traction, eg, diabetic retinopathy or myopic macular schisis, may not fare as well.
Patient selection is obviously very important. To whom should we offer surgery? For current perspectives on this topic, we are fortunate to have comments this month from Jay Duker, MD, and Rishi Singh, MD.
REFERENCES
1. Fine SL. Vitreous surgery for macular hole in perspective: Is there an indication? Arch Ophthalmol. 1991;109:635-636.
2. Colucciello M, Kokame G, Duker J. Does surgery for lamellar macular holes offer distinct gains? Retin Physician. 2012;9:20-23.
3. Gaudric A, Aloulou Y, Tadayoni R, et al. Macular pseudoholes with lamellar cleavage of their edge remain pseudoholes. Am J Ophthalmol. 2013;155:733-742.
4. Theodossiadis PG, Grigoropoulos VG, Emfietzoglou I, et al. Evolution of lamellar macular hole studied by optical coherence tomography. Graefes Arch Clin Exp Ophthalmol. 2009;247:13-20.
5. Lee CS, Koh HJ, Lim HT, et al. Prognostic factors in vitrectomy for lamellar macular hole assessed by spectral-domain optical coherence tomography. Acta Ophthalmol. 2012;90:e597-e602.
6. Inoue M, Morita S, Watanabe Y, et al. Preoperative inner segment/outer segment junction in spectral domain optical coherence tomography as a prognostic factor in epiretinal membrane surgery. Retina. 2011;31:1366-1372.
7. Casparis H, Bovey EH. Surgical treatment of lamellar macular hole associated with epimacular membrane. Retina. 2011;31:1783-1790.
8. Lee SJ, Jang SY, Moon D, et al. Long-term surgical outcomes after vitrectomy for symptomatic lamellar macular holes. Retina. 2012;32:1743-1748.
Defining the Problem Is the First Step
JAY S. DUKER, MD
Prior to discussing surgical intervention for non-FTMH, it is essential to define the entities. An LMH is a partial-thickness foveal defect that appears clinically as a round or oval, well-circumscribed, reddish lesion in the center of the fovea. Optical coherence tomography has revolutionized our ability to accurately and reliably make the diagnosis of LMH as a distinct clinical entity.
On OCT, a LMH has the following characteristics1,2:
• An irregular inner foveal contour;
• A defect in the inner retina layers of the fovea;
• Intraretinal splitting (schisis) between inner and outer retina;
• Intact photoreceptors; and
• Usually epiretinal membrane or thickened residual posterior hyaloid (Figure 1).

Figure 1. Lamellar macular hole associated with ERM. Note the loss of inner retinal tissue, schisis, and intact photoreceptors.
In contrast, the term “macular pseudohole” does not refer to a distinct clinical entity but rather to any clinical entity that appears to be a FTMH but is not. It is a clinical diagnosis made at the slit lamp with a handheld or contract lens.1
Such mimicking lesions are round, reddish, and 200 μm to 300 μm in size, found in the center of the fovea. They are often associated with good to excellent visual acuity. Because any large cystic lesion of the fovea can result in the clinical appearance of MPH, the list of underlying entities is long and includes the following: epiretinal membrane; MLH; vitreomacular traction; central serous chorioretinopathy; cystoid macular edema; myopic macular schisis; and choroidal neovascularization.
With careful clinical observation, most of the entities above can be accurately identified prior to ancillary testing. In practice, the most common entity that falls under the label of MPH is an ERM with invaginated foveal tissue (Figure 2). The OCT findings with this subtype of ERM include2 invaginated or heaped foveal edges, concomitant ERM with central opening, steep macular contour to the central fovea with near-normal central foveal thickness, and no loss of retinal tissue.

Figure 2. OCT of ERM with invaginated foveal tissue. Clinically, the eye would be in the category of macular pseudohole. Note that all retinal layers are intact.
Vitrectomy for symptomatic MPH should be considered when the underlying entity is confirmed on OCT as an etiology amenable to such surgery. An ERM with invaginated foveal tissue will respond to membrane peeling with the same visual outcome and complication rate as ERM in general; therefore, surgery should be offered using the same parameters as in any patient with an ERM.
For many years, LMH was not considered to be surgically amenable. Recently published studies have revealed that visual improvement can be achieved in some eyes with LMH; however, the visual improvement rate and ultimate visual function appear less robust than with ERM or even FTMH (Figure 3).
Figure 3. A 53-year-old man with progressively decreasing vision to 20/60 in the right eye associated with ERM and lamellar hole.
Because of this, surgery should be limited to patients who are highly symptomatic with impaired vision to a significant degree. Surgery for eyes with MLH in the setting of myopic macular schisis should probably be reserved for severe central visual loss because the success rate is lower, and the complication rates are even higher.
If surgery for LMH is undertaken, the most critical steps are complete hyaloid and ERM removal from the macula. The use of intravitreal triamcinolone acetonide (Kenalog, Alcon, Fort Worth, TX) as a surgical adjunct can be useful to identify residual hyaloid.
Some surgeons advocate peeling of the ILM in all cases to prevent recurrent ERM formation. The use of intraoperative tamponade with air or gas, followed by some length of face-down positioning remains controversial. While it carries little morbidity, without a full thickness retinal defect, it is probably of limited benefit.6
REFERENCES
1. Duker JS, Kaiser PK, Binder S, et al. The International Vitreomacular Traction Study Group classification of vitreomacular adhesion, traction, and macular hole. Ophthalmology. 2013;120:1-9.
2. Witkin AJ, Ko TH, Fujimoto JG, et al. Redefining lamellar holes and the vitreomacular interface: an ultrahigh-resolution optical coherence tomography study. Ophthalmology. 2006;113:388-397.
3. Kokame GT, Tokuhara KG. Surgical management of inner lamellar macular hole. Ophthalmic Surg Lasers Imaging. 2007;38:61-63.
4. Garretson BR, Pollack JS, Ruby AJ, Drenser KA, Williams GA, Sarrafizadeh R. Vitrectomy for a symptomatic lamellar macular hole. Ophthalmology. 2008;115:884-886.
5. Witkin AJ, Patron ME, Castro LC, et al. Anatomic and visual outcomes of vitrectomy for lamellar macular holes. Ophthalmic Surg Lasers Imaging. 2010;41:418-424.
6. Michalewska Z, Michalewski J, Odrobina D, et al. Surgical treatment of lamellar macular hole. Graefes Arch Clin Exp Ophthalmol. 2010;248:1395-1400.
Why I Don’t Perform Surgery for LMH
RISHI P. SINGH, MD
There has been renewed interest in LMH surgery following the most recent report by Shiraga and colleagues.1 In their study, the epiretinal membrane was centripetally peeled and left attached to the edge of the LMH and then laid back over the LMH so that the hole was covered with the inverted ERM tissue.
The internal limiting membrane was then removed from the surrounding tissue, an air-fluid exchange was performed, and patients were placed face down for 24 hours. The impressive results of the study demonstrated a mean improvement in visual acuity and normalization of the retinal contour.
However, when evaluating any intervention, the assessment of the natural history of a disease should be taken into account. Bottoni and colleagues performed a spectral-domain OCT assessment of the natural history of LMH and found it to be a stable macular condition.2
In highly myopic eyes with LMHs, 95.8% of patients with almost 20 months of follow-up had no significant enlargement or progression of the LMH.3 Therefore, the actual benefits of the intervention, costs of the procedure, and outcomes need to be better evaluated in a multicenter, randomized clinical trial to demonstrate benefit and prove superior outcomes to observation alone.
The current literature also lacks information on which patients with LMHs progress anatomically or visually. Therefore, identifying this subset would be most helpful when considering these interventions. In addition, the studies evaluating surgery prior to Shiraga et al have shown variable improvements in vision following the intervention.4-6 This might be because surgery for LMH fails to address the underlying pathogenesis and subsequent damage LMHs cause.
It is thought that vitreoretinal traction causes avulsion of macular tissue, and disruption of the photoreceptors in the ellipsoid zone is thought to be the reason for vision loss. Unfortunately, no procedure can actually “replace” retinal tissue because the interconnections do not reform, nor is it currently possible to regenerate lost ellipsoid zone tissue. In fact, Shiraga et al also comment that the regeneration of the IS/OS junction that is seen on SD-OCT may be caused by gliosis and not photoreceptor restoration.
Therefore, I currently do not perform surgery for LMHs at this time. With the absence of predictive factors for progression, the natural history of LMHs, and the lack of data from prospective clinical trials showing benefit, it is difficult to recommend this to patients. I commend others for actively researching solutions to this problem, and I await further results from trials to change my practice pattern. RP
REFERENCES
1. Shiraga F, Takasu I, Fukuda K, et al. Modified vitreous surgery for symptomatic lamellar macular hole with epiretinal membrane containing macular pigment. Retina. 2013;33:1263-1269.
2. Bottoni F, Deiro AP, Giani A, Orini C, Cigada M, Staurenghi G. The natural history of lamellar macular holes: a spectral domain optical coherence tomography study. Graefes Arch Clin Exp Ophthalmol. 2013;251:467-475.
3. Tanaka Y, Shimada N, Moriyama M, et al. Natural history of lamellar macular holes in highly myopic eyes. Am J Ophthalmology. 2011;152:96-99.
4. Witkin AJ, Patron ME, Castro LC, et al. Anatomic and visual outcomes of vitrectomy for lamellar macular holes. Ophthalmic Surg Lasers Imaging. 2010;41:418-424.
5. Hirakawa M, Uemura A, Nakano T, Sakamoto T. Pars plana vitrectomy with gas tamponade for lamellar macular holes. Am J Ophthalmol. 2005;140:1154-1155.
6. Michalewska Z, Michalewski J, Odrobina D, et al. Surgical treatment of lamellar macular hole. Graefes Arch Clin Exp Ophthalmol. 2010;248:1395-1400.








